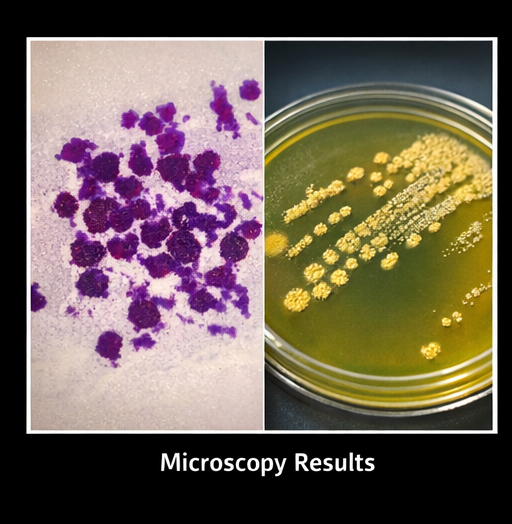

Corneal ulcer is a potentially sight-threatening ocular condition characterized by disruption of the corneal epithelium with underlying stromal inflammation and necrosis. It is most commonly caused by microbial infections, including bacterial, fungal, viral, or protozoal pathogens, often following trauma, contact lens use, or ocular surface disease. Patients typically present with pain, redness, photophobia, blurred vision, and discharge. Prompt diagnosis through clinical examination and microbiological investigations is essential to prevent complications such as corneal scarring, perforation, or vision loss.
This case report describes a middle-aged male presenting with a unilateral corneal ulcer secondary to bacterial infection following minor ocular trauma, highlighting the diagnostic approach, therapeutic management, and favorable clinical outcome with timely intervention.
Corneal ulcer, also referred to as infectious keratitis, is a serious ophthalmic emergency that requires immediate attention. It involves epithelial defect with stromal infiltration, often accompanied by inflammation of surrounding corneal tissue. The condition can rapidly progress and result in permanent visual impairment if not managed appropriately.
The etiology of corneal ulcers varies geographically and is influenced by environmental, occupational, and socioeconomic factors. In developing regions, trauma with vegetative matter and fungal infections are more prevalent, whereas in urban settings, contact lens-associated bacterial keratitis is common.
Risk factors include ocular trauma, improper contact lens hygiene, dry eye disease, eyelid abnormalities, and immunocompromised states. Early clinical recognition and targeted antimicrobial therapy are crucial in preventing adverse outcomes.
Patient History
A 42-year-old male presented to the ophthalmology outpatient department with complaints of pain, redness, and decreased vision in the right eye for 5 days. The patient reported a history of minor trauma to the eye with a foreign body (dust particle) while working outdoors.

Symptoms included:
There was no history of contact lens use, previous ocular surgery, or chronic eye disease. The patient was otherwise healthy, with no known systemic illnesses such as diabetes or immunodeficiency.
Visual Acuity:
Slit-Lamp Examination (Right Eye):

Left Eye: Normal
The findings were suggestive of an active infectious corneal ulcer.
Based on presentation, the following conditions were considered:
The acute onset, purulent discharge, and presence of hypopyon favored a bacterial etiology.
Microbiological Evaluation
Corneal scrapings were obtained under aseptic conditions and subjected to:

Results:
Additional Tests
No systemic risk factors were identified.
Based on clinical findings and laboratory confirmation, the diagnosis was established as:
Bacterial corneal ulcer (Staphylococcal keratitis) following ocular trauma
The patient was treated as an ophthalmic emergency and therapy was initiated immediately.
Pharmacological Treatment

Supportive Measures
Follow-Up
At 3 days:
At 1 week:
At 3 weeks:
Outcome
The patient demonstrated:
Corneal ulcer is a major cause of preventable blindness worldwide, particularly in developing countries. The pathogenesis involves microbial invasion following disruption of the corneal epithelium.
Etiology and Risk Factors
Common causes include:
Predisposing factors:
Slit-lamp examination remains the cornerstone of diagnosis.
Diagnostic Approach
Early microbiological diagnosis significantly improves treatment outcomes.
Management Strategies
1. Etiological Treatment
2. Empirical Therapy
3. Adjunctive Therapy
4. Surgical Intervention (if needed)
If untreated or inadequately managed, corneal ulcers may lead to:
The prognosis depends on:
Early intervention typically results in favorable outcomes, although central ulcers may leave residual visual impairment due to scarring.
Corneal ulcer is a vision-threatening ophthalmic emergency that demands prompt recognition, accurate diagnosis, and aggressive management to preserve visual function. This case reinforces the critical role of early clinical suspicion, detailed slit-lamp evaluation, and microbiological confirmation in guiding targeted therapy. Timely initiation of appropriate antimicrobial treatment not only halts disease progression but also significantly reduces the risk of complications such as corneal perforation, endophthalmitis, and permanent vision loss.
Equally important is the emphasis on preventive strategies, including the use of protective eyewear in high-risk environments, early and adequate management of ocular trauma, and patient education regarding risk factors such as poor hygiene and delayed treatment-seeking behavior. Strengthening awareness at both patient and primary care levels can facilitate earlier referrals and intervention. With a structured diagnostic approach and adherence to evidence-based management protocols, most cases of corneal ulcer can achieve favorable clinical outcomes, including restoration of corneal integrity and meaningful visual recovery, while minimizing long-term morbidity.
Read more such content on @ Hidoc Dr | Medical Learning App for Doctors
1.
Electronic Sepsis Alerts; Reducing Plaques in Coronary Arteries
2.
Ivonescimab Tops Pembrolizumab in PD-L1-Positive, Advanced NSCLC
3.
Hereditary cancer has a rare and underreported cause.
4.
New imaging guidelines for head and neck cancers, a step toward practice change
5.
BMTs that are "half-matched" are effective in treating severe sickle cell disease.
1.
Oncolytic Adenoviruses Targeting PD-L1: Advancing Cancer Immunotherapy and Tumor Control
2.
Personalized Cancer Vaccines: The Next Frontier in Precision Oncology
3.
Essential Updates in Hematology in Daily Practice
4.
The Predictive Power of Theranostics in Palliative Neuroendocrine Tumor Management
5.
Importance of Early Detection in Oncology
1.
Asian Symposium on Advancement in Hematology and Oncology
2.
Asian Symposium on Advancement in Hematology and Oncology
3.
Asian Symposium on Advancement in Hematology and Oncology
4.
International Cancer Conference
5.
Asian Symposium on Advancement in Hematology and Oncology
1.
A Comprehensive Guide to First Line Management of ALK Positive Lung Cancer - Part VII
2.
Expert Group meeting with the management of EGFR mutation positive NSCLC - Part I
3.
Current Scenario of Cancer- The Incidence of Cancer in Men
4.
Untangling The Best Treatment Approaches For ALK Positive Lung Cancer - Part IV
5.
A New Era in Managing Cancer-Associated Thrombosis
© Copyright 2026 Hidoc Dr. Inc.
Terms & Conditions - LLP | Inc. | Privacy Policy - LLP | Inc. | Account Deactivation